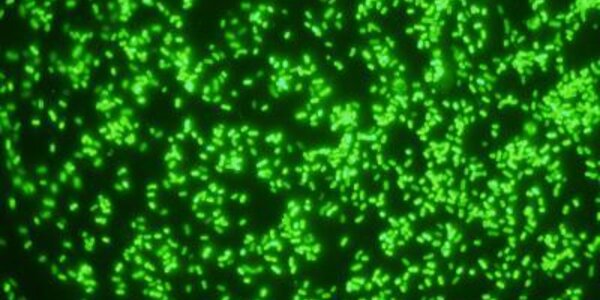
Article teaser image

Does Raw Milk Reduce Lactose Intolerance? No
Aggressive marketing by raw milk proponents has included claims that raw milk is easier to stomach for for lactose-intolerant people but a pilot study from the Stanford University School of Medicine shows no meaningful difference in digestibility between raw and pasteurized milk.
The study was small — 16 participants — but highly consistent among all and deflate some of the beneficial claims surrounding raw, or unpasteurized, milk. Relatively few people drink raw milk — it's thought to comprise less than 1 percent of milk consumed nationwide — but its share of foodborne illnesses is…